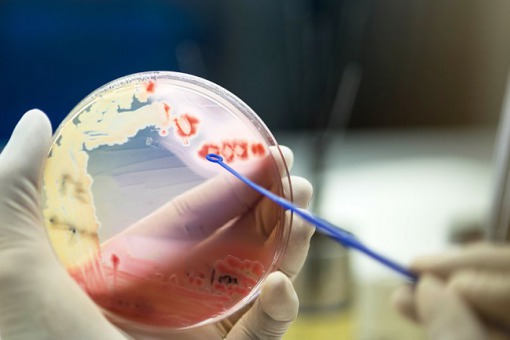

20.05.2020
Autor:
Justyna Daniliszyn
Źródło: Journal of European Academy of Dermatology and Venereology
Opracowanie: lek. med. Mikołaj Kamiński
Opracowanie: lek. med. Mikołaj Kamiński
O antybiotykooporności w ropniach mnogich pach
Antybiotyki stanowią pierwszy krok w leczeniu ropni mnogich pach, stąd też kluczowe jest określenie wrażliwości bakterii w obrębie na środki przeciwbakteryjne.
Na łamach Journal of European Academy of Dermatology and Venereology ukazała się praca w której oceniono antybiotykooporność bakterii tworzących ropnie mnogie pach.
Badacze uzyskali materiał ze 137 zmian skórnych. W sumie w 114 próbkach wykryto bakterie. W 55% przypadków wykryto bakterie gram-dodatnie, 44% gram-ujemne. 18,4% bakterii było anaerobami. Najczęściej wykrywano bakterie z rodziny enterobacteriaceae (30,7%), gronkowce (25,2%) i paciorkowce (14,1%). Najwięcej bakterii było opornych na erytromycynę (89,0%), tetracyklinę (84,7%), cyprofloksacynę (74,0%), penicylinę (70,0%), rifampicynę (69,3%) oraz klindamycynę (65,7%).
Jak wskazują badacze, w wielu próbkach wykryto oporność na antybiotyki które są zalecane jako leczenie empiryczne na ropnie mnogie pach (tj. rifampicyna, klindamycyna i tetracyklina). Stąd też, w przypadku niepowodzenia terapii należy koniecznie wykonać antybiogram, aby dobrać najskuteczniejsze leczenie.
Badacze uzyskali materiał ze 137 zmian skórnych. W sumie w 114 próbkach wykryto bakterie. W 55% przypadków wykryto bakterie gram-dodatnie, 44% gram-ujemne. 18,4% bakterii było anaerobami. Najczęściej wykrywano bakterie z rodziny enterobacteriaceae (30,7%), gronkowce (25,2%) i paciorkowce (14,1%). Najwięcej bakterii było opornych na erytromycynę (89,0%), tetracyklinę (84,7%), cyprofloksacynę (74,0%), penicylinę (70,0%), rifampicynę (69,3%) oraz klindamycynę (65,7%).
Jak wskazują badacze, w wielu próbkach wykryto oporność na antybiotyki które są zalecane jako leczenie empiryczne na ropnie mnogie pach (tj. rifampicyna, klindamycyna i tetracyklina). Stąd też, w przypadku niepowodzenia terapii należy koniecznie wykonać antybiogram, aby dobrać najskuteczniejsze leczenie.




